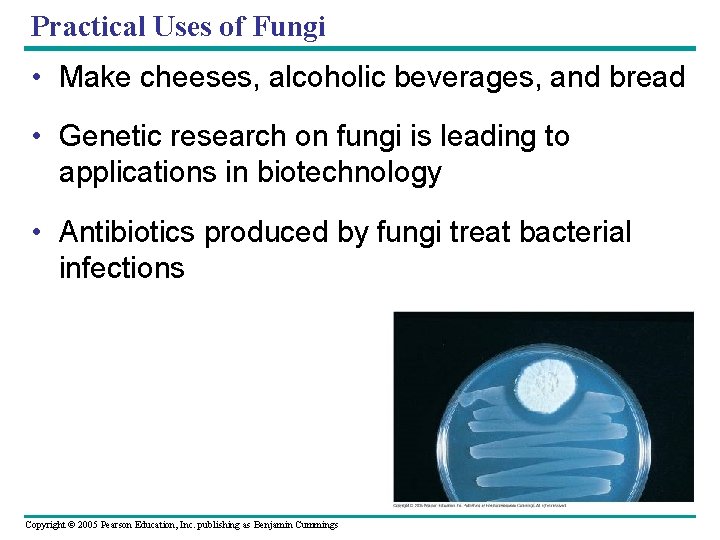
Body Structure The morphology of multicellular fungi Enhances Biology Diagrams

Economic Importance of Fungi in Agriculture Food Medicines Biology Diagrams Keystone species play a crucial role in stabilizing food chains and ecosystems. Decomposers: Though not classified in a strict trophic level, decomposers like fungi, bacteria, and certain insects recycle nutrients back into the ecosystem by breaking down organic matter. They are essential for nutrient cycling and ecosystem health. The Role of Decomposers in a Food Chain. A food chain is a linear sequence that shows how energy and nutrients are transferred from one organism to another in an ecosystem. While many people are aware of the producers and consumers in a food chain, the role of decomposers is often overlooked.

Decomposers: Dung beetles, fungi, and bacteria. Food Chains and the Environment. Food chains are an essential part of ecosystems and maintaining their balance is crucial for environmental health. If the environment is damaged by pollution, deforestation, or climate change, it can disrupt the natural food chains, leading to negative consequences.
The Role of Mushrooms in the Food Chain Biology Diagrams
In your kitchen, fungi are just tasty ingredients or a substance that ruins your leftovers. In an ecosystem, fungi play the role of decomposers -- they break down dead organic matter and return vital nutrients to the soil. Without fungi, nutrients would not cycle through an ecosystem, causing the breakdown of the entire food chain. Fungi play an important and multifaceted role in the production and processing of food, influencing various stages from cultivation to consumption. This paper explores the complex relationship between fungi and food systems, highlighting their diverse contributions. Firstly, fungi serve as essential agents in food cultivation, aiding in the breakdown of organic matter and the recycling of

Food chains describe what is eaten by whom in nature. There are countless examples, as many as there are different organisms. They show how energy and nutrients flow through ecosystems, from organisms capable of producing their own food, mostly plants, to consumers that eat plants and other consumers, and to decomposers that break down organic material to recycle the components.

What is the role of decomposers in a food chain? Biology Diagrams
Fungi and many protists and bacteria are also consumers. How are fungi important in the food chain? A hawk eats the rattlesnake. The hawk eventually dies, and bacteria and fungi decompose the body, recycling the chemicals back into the environment. Fungi aren't capable of making their own food. Their chief value in the food chain lies in

Exploring Fungi's Role in the Food Chain . Fungi play an outstanding part in many ecosystems. As part of the food chain, they interact with other organisms in intricate networks of energy flow and nutrient cycling. Fungi are vital for two essential ecological processes: decomposition and nutrient cycling. Mushrooms play a crucial and often overlooked role in the food chain, contributing to the balance and sustainability of ecosystems. Understanding the ecological importance of mushrooms is essential to appreciate the intricate workings of the natural world. Mushrooms, a type of fungus, are fascinating organisms that thrive in a wide range of habitats.. They possess unique characteristics that